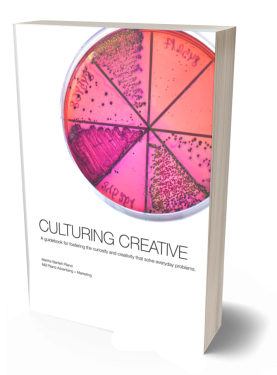
Culturing Creative book by Martha Bartlett Piland features a brightly colored Petri dish with cultures growing

New book challenges financial marketers to “Do more than just brand.”
New book challenges financial marketers to “Do more than just brand.”
Written and illustrated by Martha Bartlett Piland, CFMP
Announcing the launch of Martha Bartlett Piland, CFMP's groundbreaking new book, Don’t Just Brand There, Do Something: A Blueprint for Financial Brands That Stand Up, Stand Out and Stand the Test of Time, released on March 11, 2025. It landed on multiple best seller lists and debuted as Amazon's #1 New Release in Advertising and #1 New Release in Financial Services.
It’s the first-ever book of its kind.
A highly anticipated follow-up to Beyond Sticky, it offers a bold new approach for financial institutions seeking to differentiate themselves in an increasingly competitive market.
The book provides actionable strategies for banks, credit unions and fintechs to create unique, value-driven, action-oriented brands that resonate with customers, employees and stakeholders alike.
“Building a brand with substance beyond the quippy slogan requires finding something unique and ownable, and taking action with it,” says Bartlett Piland. “This book shows financial brands how to discover what’s different about them, then seize a position that delivers unequaled value that no one else can replicate.”
Key highlights of Don’t Just Brand There, Do Something include:
- Different types of brand positions and the pros and cons of each.
- Techniques for developing and implementing actions that deliver on the brand promise.
- How to ensure the actions translate into building a strong employer brand.
- Real-world examples and case studies from the financial industry.
Don’t Just Brand There, Do Something is available in paperback and Kindle versions here and everywhere books are sold.
media coverage
Listen in on the Bankadelic podcast with Lou Carlozo: Why Banks Suck at Branding—But Can Find Smart Ways to Do Better
Watch the book reviewed by Jack Hubbard for his regular "Book it Thursday" feature on LinkedIn by clicking here. (Shared with permission.)
Read coverage in The Credit Union Connection.
Watch a discussion from the Banker's Book Club LinkedIn Live event by clicking here.
See media reporting in the Topeka Capital-Journal.

Get off the commodity hamster wheel and create a bank brand people love
Written and illustrated by Martha Bartlett Piland, CFMP
For every banker who wants to get off the commodity hamster wheel, this first-of-its-kind book on bank marketing and branding shows the way. It’s filled with guidance on building a value-driven brand by working through all departments in the bank.
Not just for marketers, the sticky bank brand of the future is also built by human resources, operations, sales, and all other departments within the bank working together. With sections on branding, business development, customer experience, culture, and innovation, Beyond Sticky includes exercises to help bank executives break free from the commodity mindset and create new value offerings for their bank and its customers.
It’s a must read for bankers who want to stop chasing hot money and lowball pricing and start generating goodwill and loyalty like never before.
Beyond Sticky shows the way to break out of an increasingly competitive and ever-changing marketplace.
A guidebook for innovation: solving everyday problems
A guidebook for innovation: solving everyday problems
Written and illustrated by Martha Bartlett Piland
Creativity solves problems, engineers spaceships and builds brands. It makes everything in the world go. Being creative is really just being able to think differently. It’s looking at a problem in a new way and finding an unexpected solution. Culturing Creative is here to help.
Whether you’re an experienced “creative,” or someone who wants to develop more innovative thinking, this guidebook is designed to help you be a better problem solver, more strategic and—yes—creative.
This work book contains:
- 6 rules of thumb
- methods for building creative muscles
- brainstorming/problem solving techniques
- idea incubating pages
- blank pages to practice
























